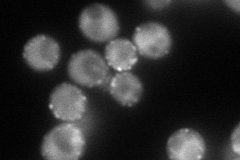
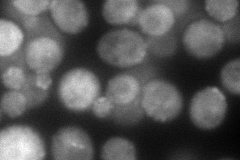
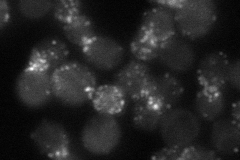
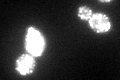

View description
Cytoskeletal protein binding protein required for assembly of the cortical actin cytoskeleton; interacts with proteins regulating actin dynamics and proteins required for endocytosis; found in the nucleus and cell cortex; has 3 SH3 domains
Localization:
Intensity:
Fold change:
Significance:
-
C’ GFP library in SD

punctate87.07 -
N' NOP1pr-GFP in SD
punctate,bud neck168.632 -
N' TEF2pr-mCherry in SD
cytosol,punctate,bud neck115.802 -
N' NATIVEpr-GFP in SD
punctate,bud neck42.4834 -
N' TEF2pr-VC and Cyto-VN in SD

punctate,bud neck60.8797 -
C’ GFP library in SD+DTT
punctate95.121.09No -
C’ GFP library in SD+H2O2

punctate102.011.17No -
C’ GFP library in Starvation Media

punctate101.491.16No -
C’ GFP library on the background of Pup2-DaMP

punctate -
C’ GFP library on the background of CCT mutant

punctate93.68351.07579No
